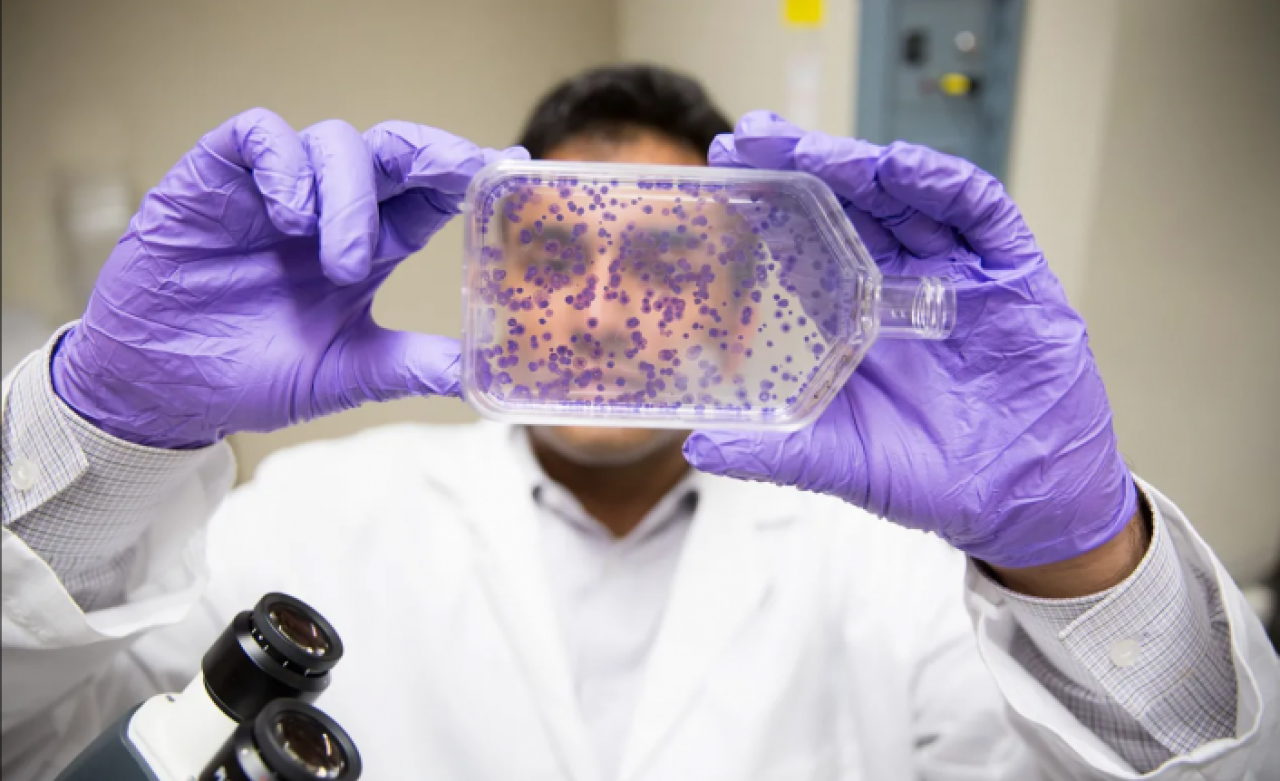
Kanser hastalığı mazi mi oluyor? Antikanser bulundu!

Hacettepe Üniversitesinden Türk bilim insanları, bağışıklık sistemi hücreleri üzerine yaptığı çalışmada önemli bir buluşa imza atıldı.
Esendağlı ve ekibi kanser hastalığında artış gösteren bir hücrenin varlığını keşfetti. Çalışma hakkında bilgi veren Prof. Dr. Güneş Esendağlı, şu ifadeleri kullandı:
"Kanser hastalarının topladığımız bağışıklık hücrelerini, farklı tekniklerle karakterize ettik. Bu hücrelerin içinde 20 binden fazla gen ifadesinin nasıl değiştiğini gördük. Diğer hücrelere göre nasıl farklı davrandıklarını, kanserle savaşta bağışıklık sistemini destekleyip desteklemediklerini gösterdik"
"Monosit dediğimiz bağışıklık hücre grubuna ait bu yeni tipteki hücreleri çeşitli tekniklerle belirledik ve topladık. Saflaştırdık, sağlıklı kişilerde göz ardı edilebilecek kadar az olduğunu, kanser hastalarında arttığını gördük."